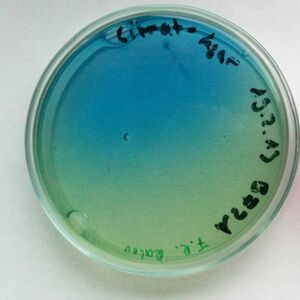

Raoultella الإنجليزية (Q495215)
جنس من بدائيات النوى
| اللغة | التسمية | الوصف | أسماء أخرى |
|---|---|---|---|
| العربية | لم تُضف التسمية |
جنس من بدائيات النوى |
|
| الإنجليزية | Raoultella |
genus of bacteria |
بيانات
Wikidata item الإنجليزية
taxon name الإنجليزية
Raoultella
year of taxon publication الإنجليزية
2001http://data.marefa.org/entity/Q1985727
١ مراجع
Imported from Wikidata item الإنجليزية
taxon rank الإنجليزية
parent taxon الإنجليزية
instance of الإنجليزية
Commons category الإنجليزية
image الإنجليزية
Raoultella planticola on Citrate agar.jpg
٦٨٢ × ٦٨٢؛ ١٥١ كيلوبايت
٦٨٢ × ٦٨٢؛ ١٥١ كيلوبايت
depicts الإنجليزية
١ مراجع
Imported from Wikidata item الإنجليزية
Gram staining الإنجليزية
LPSN URL الإنجليزية
taxonomic type الإنجليزية
named after الإنجليزية
Microsoft Academic ID الإنجليزية
Freebase ID الإنجليزية
taxon synonym الإنجليزية
وصلات الموقع
Marefa(٠ مدخلة)
ويكيبيديا(٤ مدخلات)
- dewiki Raoultella
- enwiki Raoultella
- eswiki Raoultella
- trwiki Raoultella